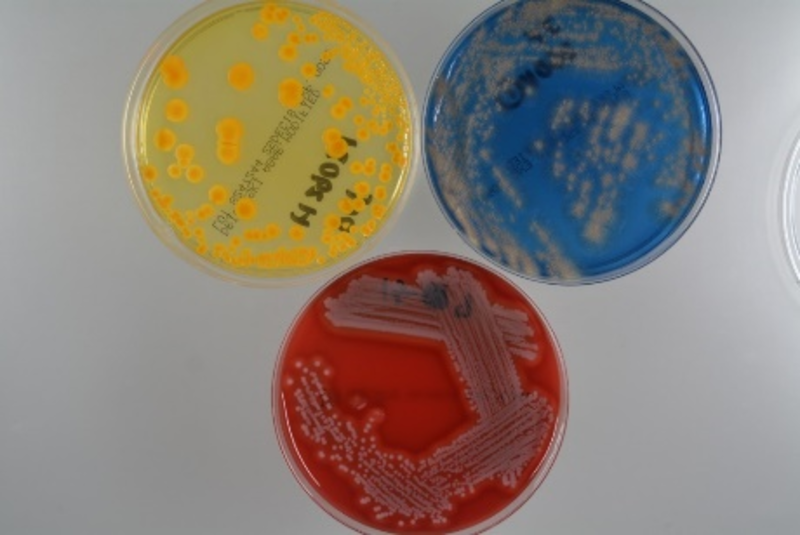

中央検査部について
中央検査部の理念
患者に繋がる診療支援を合言葉に、更に質の高い検査を目指して
中央検査部について
臨床検査は血液・尿などを用いて行う検体検査と、直接行う生体検査に大別されます。全ての患者様に迅速に正確なデータを提供できるように日々努力いたしております。また、救急医療体制のなかで、検査部としても24時間の緊急検査に対応しています。
生体検査は、検査を受ける人の身体を直接的に調べる検査です。微弱な電気信号を特殊な機器で増幅し波形として記録します。その代表的な検査が心電図検査や脳波検査です。それ以外にも各種エコー検査(心エコー、乳腺エコー、腹部エコーなど)、肺機能検査として肺活量の測定、AABR(新生児聴力検査)、CAVI(動脈硬化の検査)、呼気検査(ピロリ菌の検査)などをしています。
輸血検査、細菌検査、病理検査、骨髄などの形態検査等の幅広い分野においても、迅速な診療支援を行っています。輸血療法の安全且つ適正な実施を推進する観点から、輸血部門において血液製剤の一元管理も実施しています。また、日本検査血液学会認定の骨髄検査技師研修施設となっています。
これらを、維持、さらなる成長のために、学会、研修会などの出席や発表を積極的に推進し、精度管理調査(日本医師会精度管理・宮崎県医師会・日本臨床衛生検査技師会等)にも意欲的に参加し、検査精度の維持向上に努めています。










長安 真由美(臨床検査科長)
| 卒業年: | 平成10年 |
|---|---|
| 出身医局: | 宮崎大学 |
| 専門分野: |
病理 日本病理学会病理専門医 日本臨床細胞学会細胞診専門医 日本臨床検査医学会臨床検査管理医 日本病理学会分子病理専門医 |
検査科各部門
| 生化学・免疫血清検査 | 血液検査 | 輸血検査 | 病理・細胞診検査 |

|

|

|

|
| 生化学検査全般(AST・ALTなどで肝機能,UN・Creなどで腎機能に異常がないかのスクリーニング検査や血糖・ヘモグロビンA1cなどの糖尿病関連検査など), 免疫・感染症検査(HBsAb・Ag,HCV,HTLV-Ⅰ,FT3・FT4,TSHなどや各種腫瘍マーカ検査など) | 血液(血算、網状赤血球、機器白血球分類),凝固・線溶系検査,血液沈降速度等 | 血液型,不規則性抗体検査,交差適合試験,直接クームス検査,輸血製剤管理など | 顕微鏡検査(病理組織検査,細胞診断検査),病理解剖など |
| 一般検査 | 微生物検査 | 生理検査 | 超音波検査 |

|
|

|

|
| 尿試験紙法による尿定性検査,尿沈査,便検査,穿刺液検査(髄液・胸水)など | 感染症の原因微生物を検査(一般細菌検査,抗酸菌検査,ウィルス検査など) | 心電図,負荷心電図(エルゴメーター),24Hホルター心電図,血圧脈波など | 心臓,腹部,乳腺,血管など |